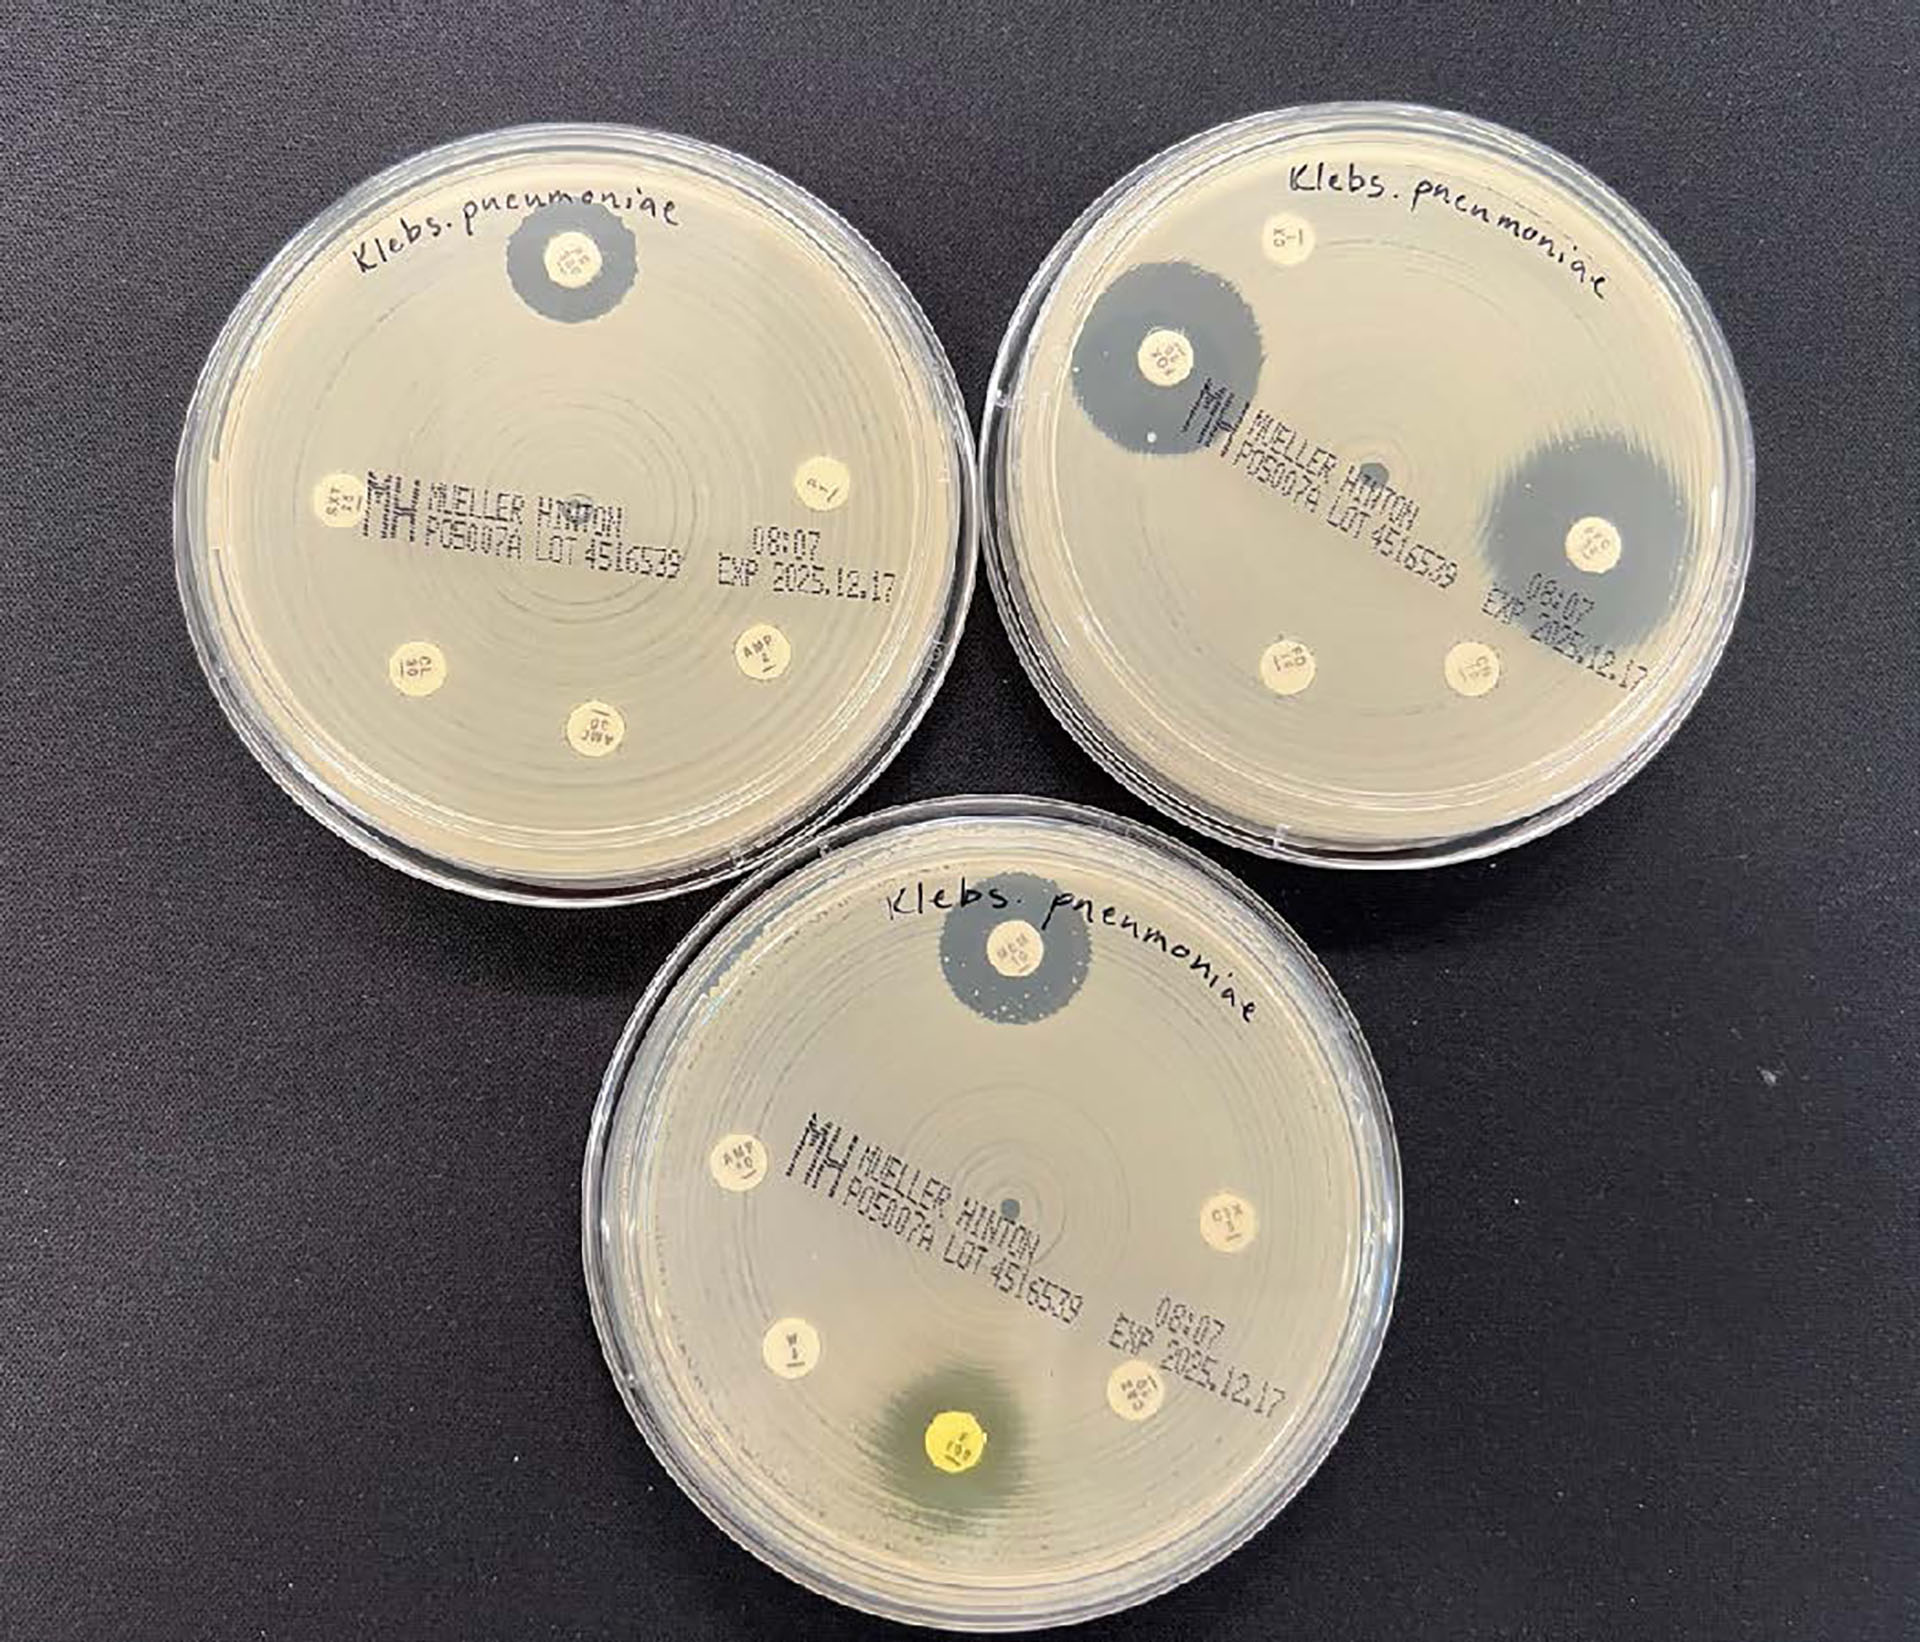

Aktuelle sykdomsutbrudd og diagnoser
Veterinærinstituttet
Pharmaq Analytiq
Første funn av karbapenemase-produserende Enterobacterales hos hund i Norge
Veterinær, dr. med. Vet, Seksjon for bakteriologi, Veterinærinstituttet
Veterinær, dr. med. Vet, Seksjon for Forskning mattrygghet og dyrehelse, Veterinærinstituttet
Multiresistent Klebsiella pneumoniae fra hund resistenstestet med agardiffusjon. Resistens viser seg ved manglende hemningssoner rundt lappene.
Foto: Bryndis Holm, Veterinærinstituttet
Bakteriearter innen ordenen Enterobacterales som Escherichia coli og Klebsiella penumoniae er naturlig forekommende i tarmfloraen, men også hyppig årsak til infeksjoner. De utvikler lett antibiotikaresistens, vesentlig grunnet evnen til opptak og utveksling av resistensgener.
Karbapenemer er beta-laktamantibiotika med bredt virkespekter mot både gram-negative og gram-positive bakterier. Karbapenemer er ofte sistelinje antibiotikabehandling for alvorlige infeksjoner med resistente bakterier hos mennesker. Det er en økning i påvisning av karbapenem-resistente Enterobacterales hos mennesker i Norge og Europa, og dette regnes som en trussel mot folkehelsen (1). Påvisning av denne type resistente bakterier er meldepliktig i Norge. Meldeplikt gjelder funn hos mennesker og dyr.
Veterinærinstituttet har nylig påvist en multiresistent Klebsiella pneumoniae i en prøve fra en hund. Prøven ble sendt inn for generell bakteriologisk undersøkelse og stammet fra en hund med kroniske hud- og øreinfeksjoner. Karakterisering av bakterieisolatet basert på helgenomsekvensering viste forekomst av genet blaOXA-48, som koder for et enzym som kan bryte ned karbapenemer. Bakterieisolatet inneholdt også mange andre resistensgener, noe som igjen kunne forklare den multiresistente fenotypen. Genetisk typing viste at bakteriestammen grupperte i Sekvens Type (ST) 307. Klebsiella pneumoniae ST307 ansees å være en «høyrisiko-klon», og den er en viktig årsak til økningen av karbapenem-resistens hos bakterier isolert fra mennesker (1).
Overvåking av antibiotikaresistens hos dyr i Norge skjer i regi av overvåkingsprogrammet NORM-VET. NORM-VET følger de obligatoriske krav til overvåking av antibiotikaresistens nedsatt i EU-kommisjonen (2), samt den nasjonale tverrsektorielle One Health-strategien mot antibiotikaresistens (2024–2033) og påfølgende sektorspesifikk handlingsplan (LMD, under arbeid) (3). I regi av NORM-VET undersøkes prøver fra storfe, gris og fjørfe annethvert år, mens prøver fra katt, hund og hest undersøkes 3. hvert år. I flere år har disse prøvene blitt undersøkt med en selektiv dyrkingsmetodikk for bærerskap av karbapenem-resistent E. coli, nå utvidet til Enterobacterales generelt. I 2023 ble det gjort funn av karbapenem-resistente E. coli fra storfe (NORM/NORM-VET 2023). Dette var første påvisning av denne resistensformen fra prøver fra dyr her i landet, og kontakt med smittebærende mennesker ble mistenkt som kilde. Besetningen ble fulgt opp av Mattilsynet og testet negativt i løpet av noen få måneder. Funn av karbapenem-resistente Enterobacterales hos produksjonsdyr og i matvarer har økt de siste årene i Europa, selv om forekomsten generelt fortsatt er lav (4).
Vi stiller spørsmål til om den beskrevne påvisningen av Klebsiella pneumoniae ST307 med blaOXA-48 representerer det første funnet av denne typen antibiotikaresistens hos hund i Norge. Det er vel kjent at mange norske dyreklinikker sender prøver til laboratorier i utlandet, og disse laboratoriene er sannsynligvis ikke klar over at enkelte former for antibiotikaresistens er meldepliktig i Norge, og har heller ikke meldeplikt til norske myndigheter. Dermed er det veterinæren eller dyreklinikken som har sendt inn prøven som etter dyrehelseforskriften er pliktig til å melde slike funn inn til Mattilsynet (5). Siden innføringen av meldeplikt i 2019, har det blitt meldt noen funn av forskjellige resistensformer til Mattilsynet (Rapporterte funn fra 2022-2024 er oppsummert i NORM/NORM-VET 2024). Imidlertid mistenkes det at funn av meldepliktige antibiotikaresistente bakterier hos dyr er underrapportert. Dette medfører at vi får en dårligere nasjonal oversikt over forekomst av disse resistensformene hos dyr i Norge, noe som er uheldig.
Referanser:
European Centre for Disease Prevention and Control. Carbapenem-resistant En - terobacterales. Third update. 3 February 2025. Stockholm 2025. https://www.ecdc.europa.eu/sites/default/files/documents/risk-assessment-carbapenem-resistant-enterobacterales-third-update-february-2025_0.pdf (21.10.2025).
European Commission. Commission implementing decision (EU) 2020/1729 of 17 November 2020 on the monitoring and reporting of antimicrobial resistance in zoonotic and commensal bacteria and repealing Implementing Decision 2013/652/EU. Off J Eur Union 2020; L387/10. https://eur-lex.europa.eu/legal-content/EN/TXT/PDF/?uri=CELEX:32020D1729&qid=1763816636515 (21.10.2025).
Helse- og omsorgsdepartementet. Nasjonal én-helse strategi mot antimikrobiell resistens. Oslo 2024. https://www.regjeringen.no/contentassets/7ae8eacec9cc4af085b - 5c113a98a0eb0/no/pdfs/strategi-antimikrobiell-resistens.pdf (21.10.2025).
EFSA BIOHAZ Panel (EFSA Panel on Biological Hazards). Occurrence and spread of carbapenemase-producing Enterobacterales (CPE) in the food chain in the EU/EFTA. Part 1: 2025 update. EFSA J 2025;23:e9336. https://efsa.on - linelibrary.wiley.com/doi/full/10.2903/j. efsa.2025.9336 (21.10.2025).
Forskrift om dyrehelse (dyrehelseforskriften). FOR-2022-04-06-631. https://lovdata.no/dokument/SF/forskrift/2022-04-06-631 (21.10.2025).
Intestinal steatose hos atlantisk laks i ferskvann
veterinærpatolog, Pharmaq Analytiq
veterinærpatolog, Pharmaq Analytiq
veterinær, Sinkaberg


Figur 1. Histologiske snitt av pylorusblindsekker fra fisk med intestinal steatose (A og C) og fra fisk med normal tarm (B og D). Tarmfoldene fremstår lysere i (A) grunnet uttalt vakuolisering av epitelcellene. I figur C ser man også at cellekjernene er kondenserte sammenlignet med kjernene i normalt epitel i figur D. Hematoksylineosin (HE).
Foto: Pharmaq Analytiq
I løpet av sensommeren og høsten 2025 mottok Pharmaq Analytiq flere diagnostikksaker fra flere produsenter med histologiske funn forenelige med intestinal steatose hos settefisk. Fiskene varierte i størrelse fra cirka 5 til 40 gram, og kom både fra gjennomstrømningsanlegg og resirkuleringsanlegg (RAS). Histologiske undersøkelser viste økt forekomst av intracellulære lipidvakuoler i epitelet i pylorusblindsekkene, svulne epitelceller og kondenserte cellekjerner (figur 1). I enkelte tilfeller ble det også rapportert om hvitfargede blindsekker ved obduksjon (figur 2). I to saker var intestinal steatose det dominerende funnet, mens de fleste øvrige saker også viste histopatologiske forandringer i andre organer, som nefrokalsinose, hjertebetennelse, svømmeblærebetennelse og tegn på systemisk bakterieinfeksjon.

Figur 2. Pylorusblindsekker fra laks. Blindsekkene (B) er tilnærmet hvite.
Foto: Marit Skjærvik
Fôrsammensetningen til oppdrettslaks har endret seg betydelig de siste tiårene fra marine råvarer på 1990-tallet til en stadig økende andel vegetabilske ingredienser. I takt med denne utviklingen har det vært økende rapportering av tarmrelaterte helseutfordringer hos oppdrettslaks, inkludert lipidopphopning i enterocyttene, betennelse/enteritt og neoplasi (1, 2). Dietter med høyt innhold av planteingredienser kan være mangelfulle eller ubalanserte med hensyn til enkelte essensielle mikronæringsstoffer (2).
Plantebasert fôr inneholder mindre av det essensielle mikronæringsstoffet kolin enn marint fôr. Kolin er nødvendig for normal lipidtransport i tarmepitelet, og mangel kan føre til opphopning av fett i epitelcellene, redusert fettabsorpsjon og hvitt, fettaktig tarminnhold – ofte mest uttalt i pylorusblindsekkene. Intestinal steatose antas å skyldes forstyrrelser i lipidtransport eller -metabolisme i enterocyttene, og kan i alvorlige tilfeller føre til fettmalabsorpsjon, steatoré og såkalt «flyteskit» (3). Forskning viser at det er en sammenheng mellom intestinal steatose og kolinmangel, og det er vist at tilstrekkelige nivåer av kolin i dietten kan forebygge eller eliminere tegn på steatose (2).
Det har vært betydelig forskningsaktivitet rundt steatose, tarmhelse og ernæring hos laks de siste årene. Tilstanden er vanlig hos oppdrettslaks, og forekomsten er særlig kartlagt hos laks i sjø gjennom større forskningsprosjekter (1). Forekomsten og alvorlighetsgraden av steatose både hos settefisk og laks i sjø varierer, og kolinbehovet påvirkes av flere faktorer slik som sesong, vanntemperatur, fôrinntak, fiskestørrelse og lipidnivåer i fôret (1, 4, 5).
Konsekvensene for laksen av de store endringene i fôrsammensetningen fra marine til vegetabilske råvarer er fortsatt ikke helt kartlagt, og det er ikke urimelig å anta at fôret er suboptimalt i forhold til laksens behov. Tarmsteatose, slik det ble påvist i disse diagnostikksakene, kan påvirke næringsopptaket fra tarmen og dermed ha konsekvenser for fiskehelse, velferd og robusthet. Histologisk scoring av tarm har vist seg å være blant de mest sensitive biomarkørene for kolinmangel (4), og histologisk vurdering av tarmvev er derfor viktig for å stille diagnosen steatose. Det er behov for videre forskning for å kartlegge behovet for kolin og andre essensielle mikronæringsstoffer hos laks i ulike livsstadier.
Referanser
Krogdahl Å, Midtlyng P, Berge G, Sæle Ø, Engelsen SB, Koppang EO et al. GutMatters. Defining and improving intestinal health in farmed salmon. Final scientific report. Ås: NMBU, 2022. (FHF project 901435).
Hansen AKG, Kortner TM, Krasnov A, Björkhem I, Penn M, Krogdahl Å. Choline supplementation prevents diet induced gut mucosa lipid accumulation in post-smolt Atlantic salmon (Salmo salar L.). BMC Vet Res 2020:16:32.
Penn MH. Lipid malabsorption in Atlantic salmon: the recurring problem of floating feces. Oslo: Tekna Fiskehelseforeningen. Fiskehelse, 2011:6-11
Siciliani D, Hubin A, Ruyter B, Chikwati EM, Thunes VG, Valen EC et al. Effects of dietary fish to rapeseed oil ratio on steatosis symptoms in Atlantic salmon (Salmo salar L) of different sizes. Sci Rep 2024;14:18006.
Siciliani D, Kortner TM, Berge GM, Hansen AK, Krogdahl Å. Effects of dietary lipid level and environmental temperature on lipid metabolism in the intestine and liver, and choline requirement in Atlantic salmon (Salmo salar L) parr. J Nutr Sci 2023;12:e61.